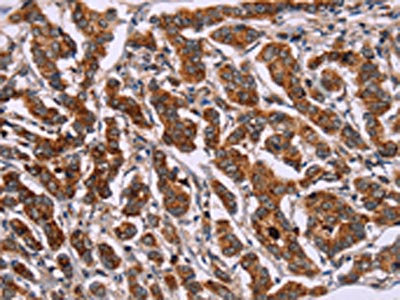

ID2 Antibody
-
中文名稱:ID2兔多克隆抗體
-
貨號:CSB-PA067380
-
規格:¥1100
-
圖片:
-
The image on the left is immunohistochemistry of paraffin-embedded Human breast cancer tissue using CSB-PA067380(ID2 Antibody) at dilution 1/30, on the right is treated with synthetic peptide. (Original magnification: ×200)
-
The image on the left is immunohistochemistry of paraffin-embedded Human liver cancer tissue using CSB-PA067380(ID2 Antibody) at dilution 1/30, on the right is treated with synthetic peptide. (Original magnification: ×200)
-
-
其他:
產品詳情
-
Uniprot No.:
-
基因名:
-
別名:bHLHb26 antibody; Cell growth inhibiting gene 8 antibody; class B basic helix loop helix protein 26 antibody; Class B basic helix-loop-helix protein 26 antibody; DNA binding protein inhibitor ID 2 antibody; DNA binding protein inhibitor ID2 antibody; DNA-binding protein inhibitor ID-2 antibody; GIG 8 antibody; GIG8 antibody; Helix loop helix protein ID2 antibody; ID2 antibody; ID2_HUMAN antibody; ID2A antibody; ID2H antibody; Inhibitor of differentiation 2 antibody; Inhibitor of DNA binding 2 antibody; Inhibitor of DNA binding 2, dominant negative helix loop helix protein antibody; MGC26389 antibody
-
宿主:Rabbit
-
反應種屬:Human,Mouse,Rat
-
免疫原:Synthetic peptide of Human ID2
-
免疫原種屬:Homo sapiens (Human)
-
標記方式:Non-conjugated
-
抗體亞型:IgG
-
純化方式:Antigen affinity purification
-
濃度:It differs from different batches. Please contact us to confirm it.
-
保存緩沖液:-20°C, pH7.4 PBS, 0.05% NaN3, 40% Glycerol
-
產品提供形式:Liquid
-
應用范圍:ELISA,IHC
-
推薦稀釋比:
Application Recommended Dilution ELISA 1:2000-1:5000 IHC 1:50-1:200 -
Protocols:
-
儲存條件:Upon receipt, store at -20°C or -80°C. Avoid repeated freeze.
-
貨期:Basically, we can dispatch the products out in 1-3 working days after receiving your orders. Delivery time maybe differs from different purchasing way or location, please kindly consult your local distributors for specific delivery time.
-
用途:For Research Use Only. Not for use in diagnostic or therapeutic procedures.
相關產品
靶點詳情
-
功能:Transcriptional regulator (lacking a basic DNA binding domain) which negatively regulates the basic helix-loop-helix (bHLH) transcription factors by forming heterodimers and inhibiting their DNA binding and transcriptional activity. Implicated in regulating a variety of cellular processes, including cellular growth, senescence, differentiation, apoptosis, angiogenesis, and neoplastic transformation. Inhibits skeletal muscle and cardiac myocyte differentiation. Regulates the circadian clock by repressing the transcriptional activator activity of the CLOCK-ARNTL/BMAL1 heterodimer. Restricts the CLOCK and ARNTL/BMAL1 localization to the cytoplasm. Plays a role in both the input and output pathways of the circadian clock: in the input component, is involved in modulating the magnitude of photic entrainment and in the output component, contributes to the regulation of a variety of liver clock-controlled genes involved in lipid metabolism.
-
基因功能參考文獻:
- Results show that self-assembly decreases the backbone flexibility of ID2 protein regions: helix-loop-helix (HLH) and the nuclear export signal (NES), that are important for interaction with basic-HLH transcription factors or for nucleocytoplasmic shuttling. PMID: 29642431
- the results of the present study suggest that lncRNA H19 regulates the expression of ID2 through competitive binding to hsamiR19a and hsamiR19b, which may serve a role in acute myelocytic leukemia cell proliferation. PMID: 28765931
- ID2 is localized to peritoneal mesothelial and stromal cells of women with and without endometriosis. ID2 mRNA expression is lower in peritoneum adjacent to the endometriosis lesions compared to distal sites PMID: 27385728
- The ID2 gene expression was increased in the most advanced stage of endometriosis and in ovarian endometriomas. Considering that the genes studied participate either directly or indirectly in cellular processes that can lead to cell migration, angiogenesis, and inappropriate invasion, it is possible that the deregulation of these genes caused the development and maintenance of ectopic tissue. PMID: 28678915
- Data indicate that the expression level of ID2 in GBM cells can predict the sensitivity of GBM-derived tumor cells to decreased glucose levels. PMID: 28206987
- Results show that ID2 signaling was involved in BMP4-induced hepatocellular carcinoma proliferation and that Id2 was directly upregulated by BMP4, resulting in the mediated expression of cell cycle regulatory protein of CDKN1B. PMID: 28543546
- EYA4 functions as tumor suppressor gene in pancreatic ductal adenocarcinoma via repressing beta-catenin/ID2 activation, and was an independent prognostic factor in PDAC. PMID: 27378242
- Results show that MLL-AF9 reduces Id2 and increases E2-2 expression to drive and sustain leukemia stem cell potential in MLL-rearranged acute myeloid leukemia (AML). Low expression of Id2 or of an Id2 gene signature is associated with poor prognosis in not only MLL-rearranged but also t(8;21) AML patients. PMID: 27374225
- We further demonstrated, for the first time, that the degree of hypoxia-induced CSC-sphere formation (CD44(+) subpopulation) in vitro and of tumor metastasis/dissemination in vivo were markedly suppressed by knocking down Id2 expression PMID: 26965643
- ID2 knockdown triggers important changes in cell behavior, that is, it significantly reduces the expression of N-cadherin, vimentin and Snail, induces E-cadherin expression and leads to a more differentiated phenotype exemplified by changes in cell shape. ID2 therefore represents a potential therapeutic target during salivary gland cancer progression PMID: 27364596
- cell invasion drastically increased with increased expression and activity of MMP2. Immunoprecipitation revealed a direct interaction between ID2 and zinc finger transcription factor, snail family transcriptional repressor 1 (SNAIL1) PMID: 27807072
- High Id2 expression is associated with Neuroblatoma. PMID: 25771836
- ID2 binds to the VHL ubiquitin ligase complex, displaces VHL-associated Cullin 2, and impairs HIF2alpha ubiquitylation and degradation PMID: 26735018
- Downregulation of the Id2 gene by RNAi could increase the chemosensitivity of glioblastoma cells. Id2 could be a good molecular target for glioblastoma gene therapy. PMID: 25773386
- role of Id2-TGFbeta crosstalk in reversible adaptive plasticity in neuroblastoma PMID: 24376712
- Importantly, the distinct ID2 expression patterns in acute leukemias (AL) indicate a specific deregulation of ID2 in the various types of AL and may support subtyping of AL. PMID: 24292846
- ID2 was involved in cancer cell responses to Arsenic Tri-Oxide (ATO). Increased expression of ID2 was found in cancer cells following ATO treatment. In addition, specific silencing of ID2 enhanced cell apoptosis induced by ATO treatment. PMID: 25076250
- study shows that Id2, Id3 and Id4 are each able to overcome TGF-beta dependence, and establish a role for Ids as key mediators of TGF-beta melanomagenesis PMID: 24343358
- Id2 overexpression in neural stem cells is associated with inhibition of the Notch effector Hey1 and glioma formation in the brains of mice. PMID: 24425046
- PreBII large cells in adults, but not in children, showed highly upregulated expression of the differentiation inhibitor, inhibitor of DNA binding 2 (ID2), in absence of changes in expression of the ID2-binding partner E2A. PMID: 23825313
- A reduction in Id2 is critical for transforming growth factor (TGF)beta1-induced alpha-SMA expression in renal proximal tubule epithelial cells but is not sufficient in it self to induce alphaSMA (smooth muscle actin) even in the context of reduced E-cadherin. PMID: 23320068
- ID2 expression affects the susceptibility hepatoma cell lines to an HDAC inhibitor by regulating the expression of anti-apoptotic genes. PMID: 23403953
- Id2 induces squamous cell carcinoma tumor growth and proliferation through the NF-kappaB/cyclin D1 pathway. PMID: 22835384
- Higher ID2 expression was associated with advanced breast cancer. PMID: 23645773
- upregulated H19 increases bladder cancer growth by regulating ID2 expression PMID: 23399020
- Data indicate that ID2.K47A, ID2.Q55A and ID3.R52A, ID3.R60A had wildtype like expression levels in E. coli. PMID: 23119064
- preliminary X-ray data analysis of the human ID2 homodimer PMID: 23143248
- A critical role of Id2 is revealed in the control of effector CD4 T cell population size and the development of T helper (Th) cell type 17-mediated autoimmune encephalomyelitis. PMID: 22745378
- ID2 in nucleus was increased in nasopharyngeal carcinoma when compared with that in normal nasopharynx tissues. Higher expression level of nuclear ID2 was significantly associated with tumor size, lymph node metastasis, and clinical stage. PMID: 22551584
- Id2 mutations do not seem to be involved in ureteropelvic junction obstruction. PMID: 21927809
- Id2 and Id4 regulated glioblastoma multiforme neurosphere differentiation through downregulating of another bHLH family member, the oligodendroglial lineage-associated transcription factors (Olig) 1 and 2 PMID: 22380883
- This review reported that ID2 protein is a negative transcription factor regulating oligodendroglia differentiation. PMID: 22253220
- Findings indicate that Id2 functions as a proproliferative gene that antagonizes p53-mediated cell cycle regulation in NPCs and may contribute to the malignant proliferation of glioma-derived tumor stem cells. PMID: 21608079
- Large scale RNAi screen reveals that the inhibitor of DNA binding 2 (ID2) protein is repressed by p53 family member p63 and functions in human keratinocyte differentiation. PMID: 21478550
- AMP-activated protein kinase (PRKAA1/2, aka AMPK) mediates the stress-induced proteasome-dependent loss of ID2 at high stress levels. PMID: 20876741
- expression of vFLIP decreased the expression levels of Id2 and Id3 as well as cyclin E and cyclin A compared with the vFLIP-null cells PMID: 20512523
- ID2 can interact with the canonical clock components CLOCK and BMAL1 and mediate inhibitory effects on mPer1 expression PMID: 20861012
- T cell development is impaired by Id2, most likely by sequestering HEB, whereas NK cell development is promoted by increasing a pool of CD1a-CD5+ NK cell progenitors, which together with IL-15 differentiate into mature NK cells PMID: 20483740
- VEGF165 may partially inhibit TGF-beta1-induced epithelial-mesenchymal transition by upregulating the expressions of BMP-7 and Id2. PMID: 19180920
- Metastatic tumor cells overexpress c-myc, leading to upregulation of Id2 expression; the aberrantly elevated amount of Id2 represses SEMA3F expression and, as a consequence, enhances the ability of tumor cells to migrate and invade. PMID: 20388805
- Hypoxia-induced ID-2 may contribute to joint destruction in rheumatoid arthritis patients by promoting synovial fibroblast-dependent osteoclastogenesis. PMID: 19950294
- Id2 is critical for cellular proliferation and is the oncogenic effector of N-myc in human neuroblastoma. PMID: 11782392
- determination as a novel target of transcriptional activation by EWS-ETS fusion proteins in Ewing family tumors PMID: 12447693
- upregulation is mediated by the chimeric EWS/ets protein in Ewing sarcoma PMID: 12527902
- We found no correlation between MYCN and ID2 expression in neuroblastoma cell lines or tumor specimens. However, we did find a significant positive correlation between MYC and ID2 expressions in both MYCN-amplified and single-copy tumor specimens PMID: 12545167
- Id2 is up-regulated during dendritic cells development in vitro and crucial for the development of distinct dendritic cells subsets in vivo PMID: 12598895
- Transcriptional regulation of ID2 by the MycN oncoprotein is unlikely to be a seminal molecular event resulting in a highly malignant neuroblastoma phenotype. PMID: 12670915
- Mad expression and Id2 down-regulation are important events during the TGF-beta cytostatic program in epithelial cells. PMID: 12824180
- The decreased level of Id2 was associated with growth suppression and does support the prevalent conception of the action of Id2 as a stimulator of cell growth PMID: 14582708
- ID-2 appears to act as an important protein for the maintenance of a differentiated and noninvasive phenotype in normal and transformed breast cells. PMID: 14612502
顯示更多
收起更多
-
亞細胞定位:Cytoplasm. Nucleus.
-
組織特異性:Highly expressed in early fetal tissues, including those of the central nervous system.
-
數據庫鏈接:
Most popular with customers
-
-
YWHAB Recombinant Monoclonal Antibody
Applications: ELISA, WB, IHC, IF, FC
Species Reactivity: Human, Mouse, Rat
-
Phospho-YAP1 (S127) Recombinant Monoclonal Antibody
Applications: ELISA, WB, IHC
Species Reactivity: Human
-
-
-
-
-